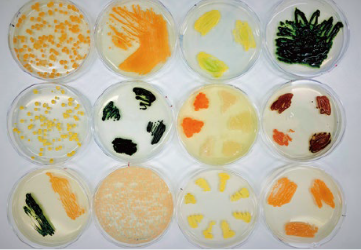

Phycoil Biotechnology
International (PBI), USA
PBI is a US-based biotechnology company
that develops unique bio-products using its proprietary strain collection, optimization process, and world-class expertise in synthetic and industrial biotechnology.
Conscious Design
We screen our microbial library to identify strains that produce either precursors or desired end products. Then, we use bioinformatics tools to understand metabolic pathways and design pilot studies to modulate the desired products.

Pathway Engineering
We generate strains to be used in the production of high-value products through our
expertise in cell adaptation, improvement, and programming.

Phycoil Biotech Korea (PBK), Gongju
Phycoil Biotech Korea offers commercial-scale production and in-house oil refining capability to supply sustainable high-value ingredients.
100% nameplate capacity
GMP-certified oil
refining process
Supercritical CO2
extraction capability
Phycoil Biotech Korea (PBK), Seoul
PBK H.Q Office is located in Gangnam, Seoul,
and establishes integrated management strategies for
PBK and PBI, and carry out marketing, public relations.